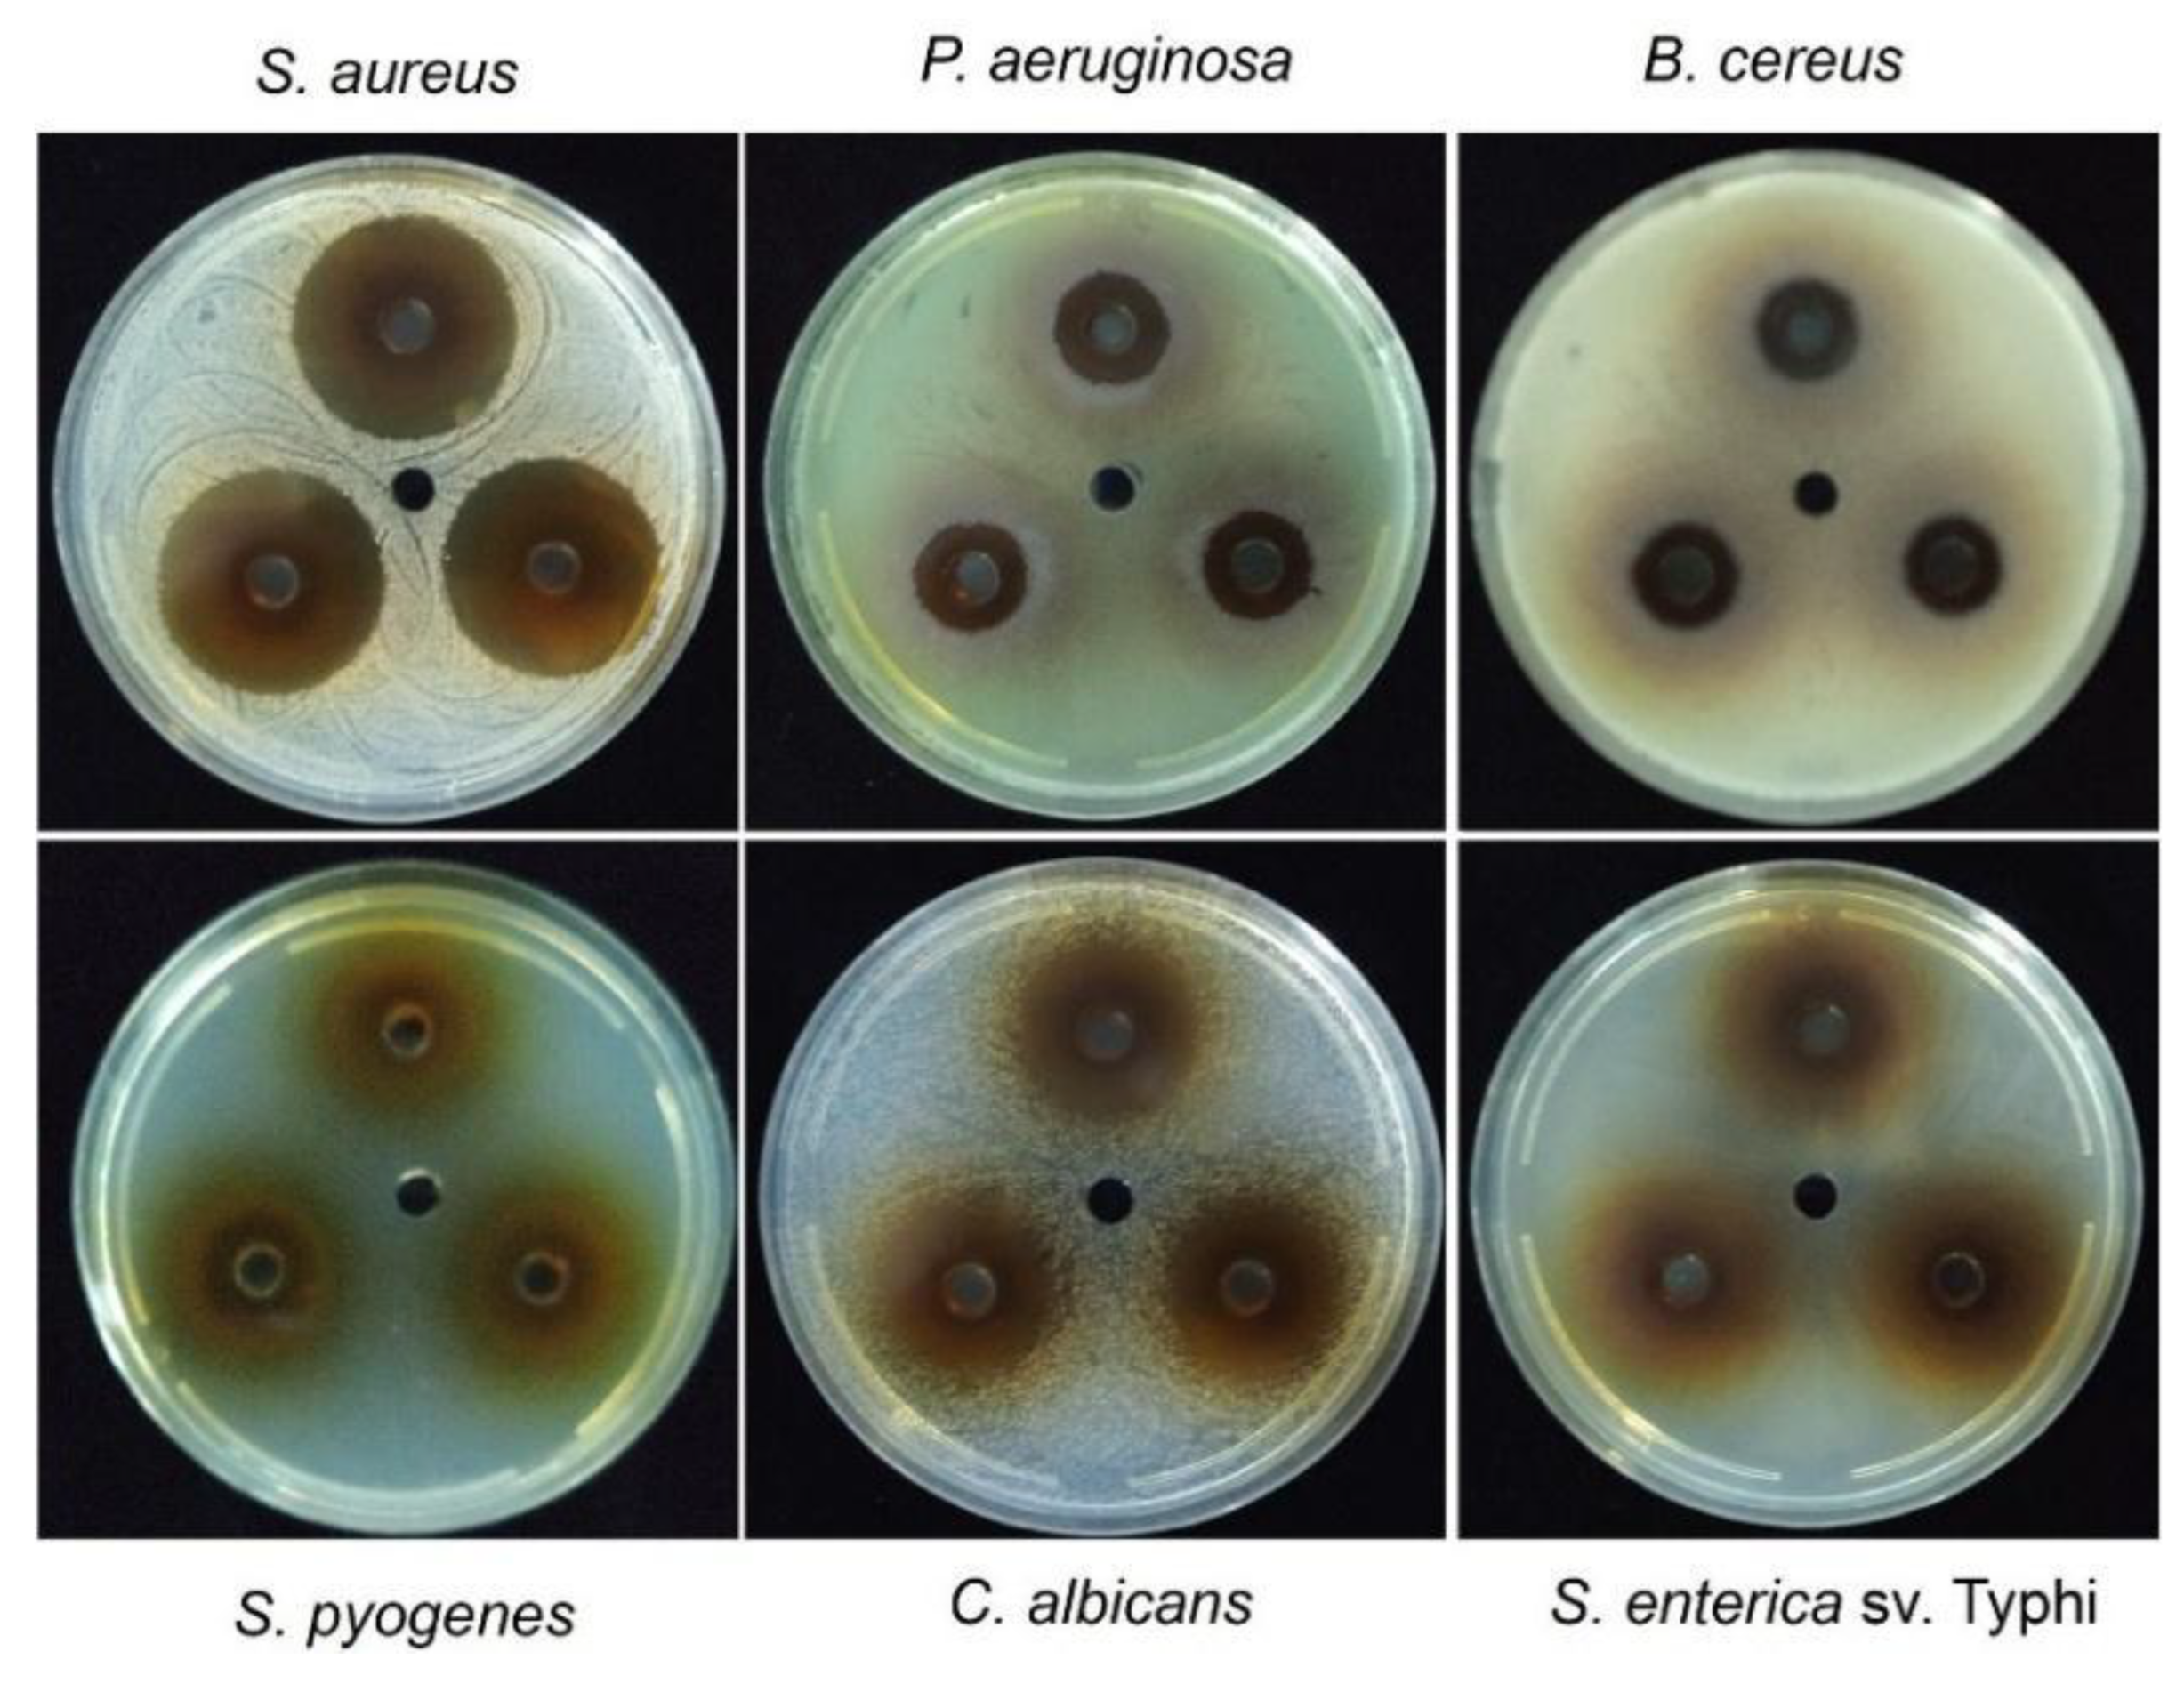
Preprints 189842 g003
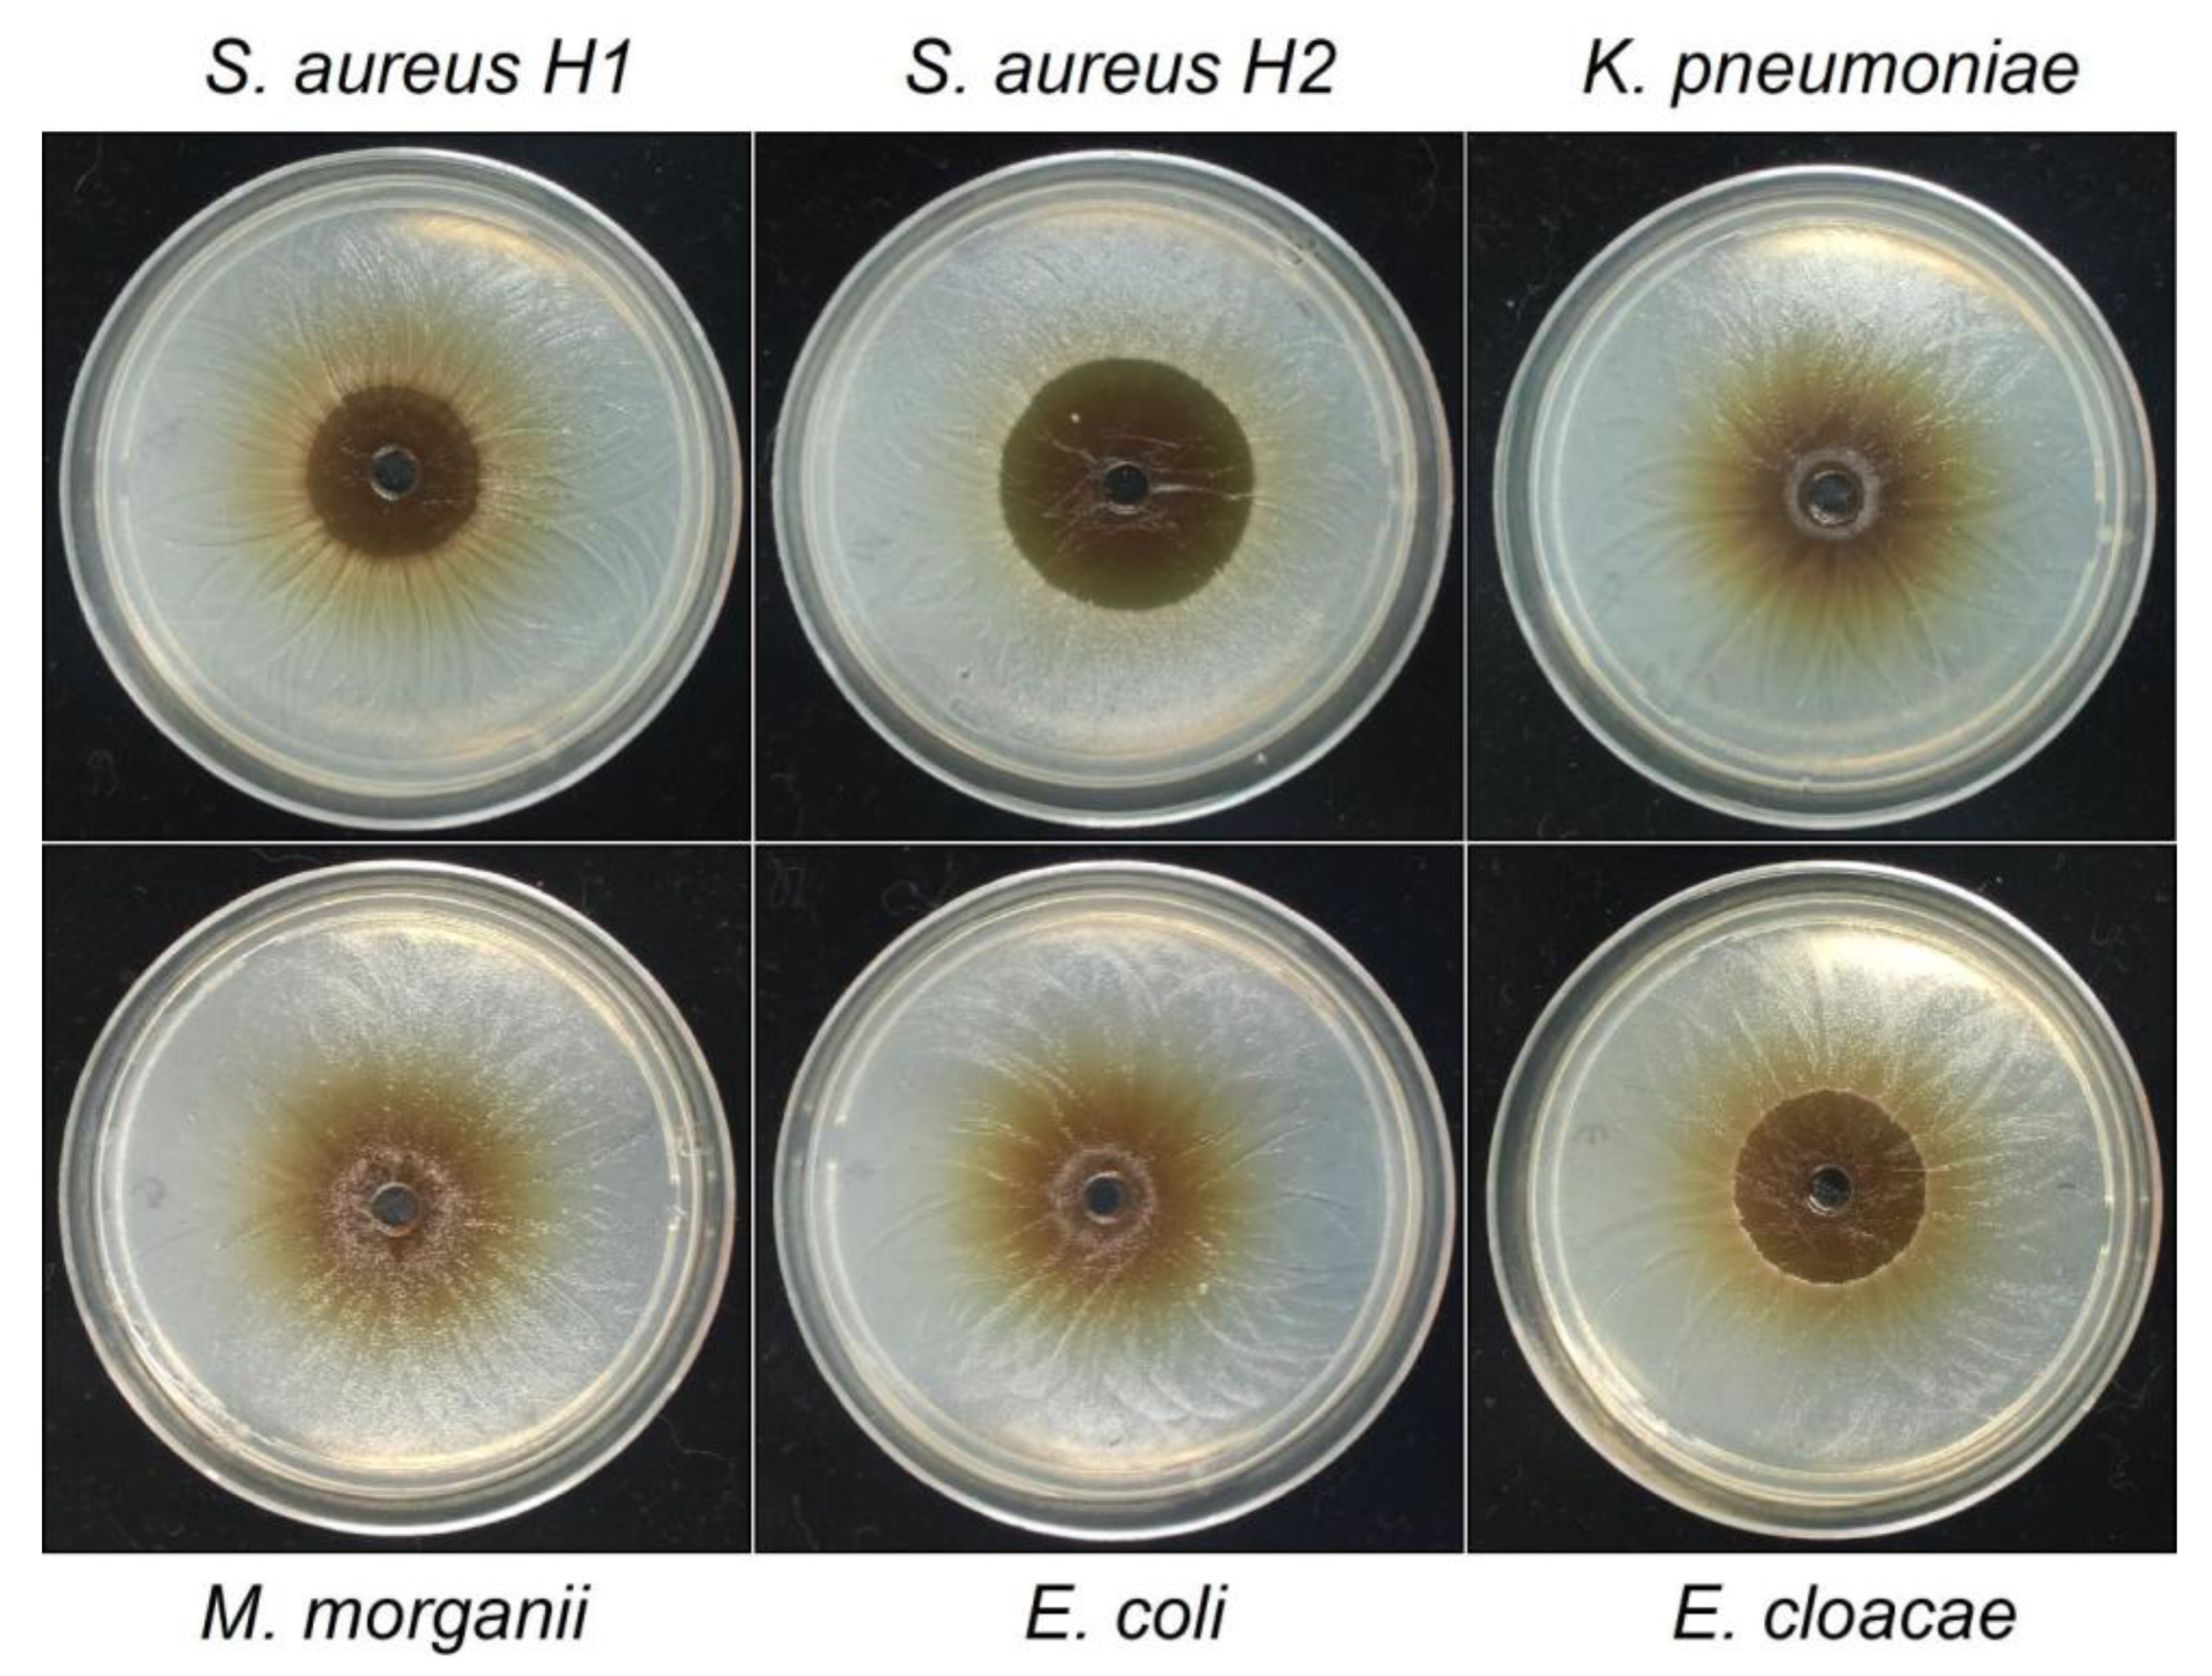
Preprints 189842 g004

1. Introduction
An enigmatic group of plants, the so-called mistletoes, has been described in the literature. Mistletoes are a type of parasitic plant comprehending around 1,600 species grouped in four families, Loranthaceae, Misodendraceae, Santalaceae and Viscaceae, among which the Loranthaceae family is the largest, with 900 or more species. These plants are vegetables that, unable to satisfy their nutritional demands on their own, obtain the nutrients they require at the expense of another plant, called a host [
1].
The genus Tristerix comprises 11 described as hemiparasitic species belonging to the Loranthaceae family that grow only in South America from Chile and Argentina in the south to Colombia and Ecuador by the north of South America. Two of these species grow in Chile. The Tristerix aphyllus that grows on cacti, while the Tristerix corymbosus species grows on a wide variety of hosts, among the most common being poplar, huayún, willow and olive trees.
Figure 1.
T. corymbosus on Salix babilonica collected for this study. Locally known as quintral, quitral, cutral ñipe o liga. (a) Samples were collected in El Paico Town, El Monte, RM, Chile. (b) T. corymbosus hosted in S. babilonica forms massive growth that in the long term kills the three. (c) The Chilean mistletoe T. corymbosus produces red inflorescences organized in corymbs, from January through September. (d-e) detail of ripe and row fruits of T. corymbosus. (f) During germination, T. corymbosus seeds stick to branches and start producing a haustorium that penetrates tree’s tissues.
Figure 1.
T. corymbosus on Salix babilonica collected for this study. Locally known as quintral, quitral, cutral ñipe o liga. (a) Samples were collected in El Paico Town, El Monte, RM, Chile. (b) T. corymbosus hosted in S. babilonica forms massive growth that in the long term kills the three. (c) The Chilean mistletoe T. corymbosus produces red inflorescences organized in corymbs, from January through September. (d-e) detail of ripe and row fruits of T. corymbosus. (f) During germination, T. corymbosus seeds stick to branches and start producing a haustorium that penetrates tree’s tissues.
T. corymbosus (sin.
T. tetrandus), the most common species of Chilean mistletoe, is typically found between latitudes 30°S and 40°S [
1]. It is characterized by its striking red or orange tubular hermaphroditic flowers, which attract honeybees and hummingbirds for pollination. Its fleshy fruits are consumed and dispersed by birds, with seeds adhering to tree branches through mucilaginous sap after digestion.
Germination begins when a haustorium develops, penetrating the tree’s endophytic system. T. corymbosus often parasitizes poplar and willow trees in central and southern Chile, which are more susceptible than native species, and can lead to the collapse of infested trees over time.
Quitral (also known as quintral, cutral, ñipe o liga) is one of the species used by the Mapuche people for its healing properties [
2]. In traditional medicine, has long been utilized for its antioxidant, astringent, hemostatic, hypocholesterolemic, wound-healing, digestive, and anti-inflammatory activities [
2]. Unlike the Viscum
album, its European relative mistletoe species [
3,
4,
5,
6],
T. corymbosus has not been extensively studied for its use in phytotherapeutics in complementary and alternative medicine (CAM). However, few studies have described the phytochemical composition and biological activities associated with
T. corymbosus and related native species. Simirgiotis’s studies described for the first time the phenolic compounds of Chilean mistletoe (
T. corymbosus), endemic to the VIII region of Chile (parasiting poplar). This study revealed the presence of 36 compounds, 30 of which are present in mistletoe leaves, including several caffeic acid derivatives, procyanidins, various flavonoids, among others. Six anthocyanins were detected in its mistletoe flowers. The researchers found significant differences between leaves and flowers in the total phenolic content and antioxidant activity of this species [
7].
Recently, Torres
et al. (2019) investigated the antioxidant properties of
T. corymbosus grown on three different host plants. This study revealed the phytochemical composition of various extracts and plant parts, such as glycosides, sterols, terpenoids, and quinones, in addition to high levels of total phenols and total flavonoids. Also, Torres
et al. reported their reducing power [
1].
In this work, we evaluated antimicrobial activity of the hydroalcoholic extract from leaves, flowers and fruits of T. corymbosus collected in central Chile. The phytochemical composition of each extract was qualitatively examined by using a battery of standard reactions. The leaves extract was further characterized as it presented the higher antimicrobial activity against the Gram-positive S. pyogenes, although it was inactive against E. coli, a Gram-negative bacterium. The extract was precipitated by adding methanol and three fractions obtained. Again, the fraction presenting the higher antimicrobial activity was further characterized against a panel of bacteria and by HPLC-MS, providing a complex phytochemical composition rich in lipidic compounds.
2. Results
2.1. Different Types of Secondary Metabolites Are Present in the Hydroalcoholic Extract of Leaves, Flowers and Fruits of T. corymbosus
The plant powder was soaked in 70% ethanol as detailed in the materials and methods section. In a preliminary effort to find enhanced antimicrobial activity, smaller scale (50 or 100 mL) hydroalcoholic extracts were produced from the leaves, flowers, and fruits of
T. corymbosus. Before exploring the biological activity of
T. corymbosus, a qualitative analysis of its phytochemical composition was conducted. The findings suggested a potentially detectable presence of 6 compound families in the leaves extract, 4 compound families in the flower extract, and 8 compound families in the fruit extract.
Table 1 provides a detailed view of the extracts’ composition. The extracts from the fruits exhibited the greatest diversity, containing 8 chemical families, whereas the leaves’ extract showed 6 chemical families in the hydroalcoholic extract, and the flowers’ extract included just 4 chemical families. All extracts showed positive results for steroids and terpenes in the Liebermann-Burchard test and for tannins and phenolic compounds in the ferric chloride test. As anticipated, the fruit extract was the sole extract that tested positive for carbohydrates. Information regarding qualitative compositions can be found in
Table 1.
2.2. Preparation of Hydrosoluble Fraction from a Hydroalcoholic Extract from T. corymbosus
Plant powder was soaked in 70% ethanol as outlined in the materials and methods section. In a preliminary effort to investigate antimicrobial properties, small-scale (50 or 100 mL) hydroalcoholic extracts were generated from the leaves, flowers, and fruits of T. corymbosus.
The extracts were rotovaped and tested for antimicrobial effects against E. coli and Streptococcus pyogenes (see Table1) using an agar diffusion assay as described in detail below in section 2.3 and 4.4. In this case, only 2 bacteria were utilized, a Gram-negative and a Gram-positive to screen for the fraction with the higher activity
Table 2.
Activity of the row hydroalcoholic extract against S. pyogenes and E. coli.
Table 2.
Activity of the row hydroalcoholic extract against S. pyogenes and E. coli.
| extract |
microorganism |
inhibition haloes (mm) |
standard error |
| leaves |
S. pyogenes |
28.9 |
3.1 |
| E. coli |
6.0 |
0.0 |
| flowers |
S. pyogenes |
13.7 |
2.5 |
| E. coli |
6.0 |
0.0 |
| fruits |
S. pyogenes |
20.3 |
1.7 |
| E. coli |
6.0 |
0.0 |
| Bacterial strains correspond to Streptococcus pyogenes ISP36900 and E. coli ATCC25922 |
Because antimicrobial effect was higher in leaves extract against Gram-positive
S. pyogenes and because leaves are abundant and easy to collect, it was decided to prepare a higher scale hydroalcoholic extract starting with 100g of leaves powder in 1L of 70% ethanol. The extract was vac-filtered and rotovaped from 60 °C to 70 °C. When the extract was reduced to around 100 mL of mostly water, 300 mL of methanol was added to keep rotovaping to extract remaining water. Incidentally, the addition of methanol produced a muddy precipitate which was filtered, dried at 37 °C and kept as a brown powder. At the same time, a tar-like insoluble fraction remained at the bottom of the original flask; such an insoluble fraction was also kept for further characterization. The flowthrough fraction (in methanol and water) was rotovaped to dry. Finally, the three fractions tested soluble in 70% ethanol or water and were kept in an amber-color container for further characterization. Schematic representation of steps followed from extraction to antimicrobial activity essays and identification of molecules is shown in
Figure 2.
2.3. Hydrosoluble-Powder Fraction Obtained from the Hydroalcoholic Extract of T. corymbosus Shows Potent Antimicrobial Effects
To test the antimicrobial activity of the hydrosoluble fraction (HSF) obtained from the ethanolic extract of
T. corymbosus the well diffusion was performed by adding 35 µL of HSF (150 mg/mL) in each of a 6 mm well, formed in a Petri plate. As shown in
Figure 3, the HSF presents inhibitory effects against Gram-positives, Gram-negative and yeast. The results are summarized in Table 3 where the higher effect is evidenced for the Gram-positive
S. aureus and the yeast
C. albicans. Importantly, the extract also presented activity against
Pseudomonas aeruginosa and
Salmonella enterica serovar Typhi.
Antimicrobial activity of HSF was also quantitatively evaluated by evaluating minimal inhibitory concentration. Such procedure confirmed a potent effect against S. aureus and C. albicans, as well as antimicrobial effects observed in the diffusion assay for the other microorganisms. In the case of Gram-negatives the antimicrobial effects depend on the species and even the serovar, as the HSF is somehow active against Salmonella enterica serovar Typhi but less active against S. enterica serovar Typhimurium.
2.4. Antimicrobial Effects of the Hydrosoluble-Powder Fraction of T. corymbosus in Clinical Isolated Bacteria
To test the ability of the HSF to inhibit growth of clinical isolated bacteria, antimicrobial activity was tested against
S. aureus and four Gram-negative clinical isolated bacteria, ranging from resistant to multiresistant, see detail in
Table 4. The
S. aureus strains presented different degrees of sensitivity to HSF. When it comes to Gram-negative bacteria, only
E. cloacae showed a potent inhibition. Importantly, the HSF presents antimicrobial activity against resistant and multiresistant bacteria that spread between high to moderate (see
Figure 4 and
Table 4).
2.5. LC-MS Analysis and Identification of T. corymbosus Ethanolic Extracts
Figure 5A shows the chromatogram obtained in positive polarity, in which a high density of peaks was observed, with greater intensity in the most hydrophobic region of the gradient. In negative polarity, a similar trend was observed, although the peaks exhibited low chromatographic resolution (
Figure 5B). The tentative identification of some of the peaks is detailed in
Table 5, which also includes the molecular formula, theoretical m/z (m/z-theo) and experimental m/z (m/z-exp) signals, the mass error in ppm between m/z-theo and m/z-exp, the modified cosine (MQ) score provided by GNPS, and the chemical classification of the identified compounds.
In positive polarity, the compounds identified corresponded mainly to lipids such as LPC(16:0) and DAG(16:0/18:4), as well as tetrapyrrolic pigments characteristic of chlorophyll degradation, including 3,10S-hydroxypheophorbide A, pheophorbide A, pyropheophorbide A, and pheophytin A. 13-Docosenamide, a fatty acid amide, was also identified, along with diethyl phthalate, a phthalic acid ester that is likely an exogenous contaminant.
In negative polarity, the identifications corresponded mainly to glycerophospholipids, including phosphatidylglycerols such as PG(16:1/18:3), phosphatidylinositols such as PI(16:0/18:2), and phosphatidic acids such as PA(18:2/18:2), all of which are typical components of biological membranes. The predominance of these phospholipids in negative mode is consistent with their anionic nature, derived from the presence of phosphate groups that ionize efficiently under these conditions. Co-elution of compounds was observed in both polarities, and several peaks shared the same identification, likely due to the presence of isomers. Formulae of most representative compounds found in the HSF are depicted in
Figure 6.
2.6. The Hydro-Soluble Extract of T. corymbosus Produces Bacterial Dead Mainly by Affecting Membrane Integrity
Because of the high content of lipidic chemical species in the hydro-soluble extract it was hypothesized that membrane damage could be important for the antibacterial effects. Therefore, the LIVE/DEAD BacLight Bacterial Viability Kit was used (
Figure 7). The protocol includes the use of two dyes that stain nucleic acids. The SYTO 9 dye penetrates all cells staining green cells with intact membranes. While propidium iodine only penetrates cells with damaged membranes ousting SYTO 9, resulting in red fluorescence, as depicted in
Figure 7A-B. The green/red fluorescence ratio was used to determine the percentage of viability and membrane integrity. As seen in
Figure 6, in untreated bacteria, green fluorescence predominates (compare
Figure 7A upper with lower panel). Analogously, in extract treated bacteria red fluorescence predominates compared to the untreated group (compare
Figure 7A lower with upper panel).
Figure 6B depicts the affinity of SYTO 9 staining toward nucleic acids, as it penetrates inside intact cells. While SYTO 9 also penetrates through the membrane of damaged cells, SYTO 9 is displaced from nucleic acids by PI staining which possesses higher affinity and emits red light. Higher red fluorescence compared to green (
Figure 7C) is indicative of 11.9% live cells as the viability is extrapolated from a calibration curve (
Figure 7D). Therefore, over 88% of cells were damaged at the cellular membrane.
3. Discussion
There are few reports describing the phytochemical composition of
T. corymbosus extracts and related species. This work describes a fractionated extract with important antimicrobial effects mainly against Gram-positive bacteria such as
S. aureus,
S. pyogenes and
B. cereus, but also antimicrobial effects on some enterobacterales such as S.
Typhi. In addition, antimycotic activity was observed for
C. albicans. Importantly, the antimicrobial effects were confirmed for all clinical isolated
S. aureus tested and observed for enterobacterales such as
E. cloacae and with less intensity for
Klebsiella and
Morganella. The level of sensitivity to the HS extract was especially higher for
S. aureus for both, the standard or clinical isolated. The fact that plant extracts are more active against Gram-positive find support in the literature regarding magnitude of the effects against Gram-positive bacteria, number of plants with effects on Gram-positive versus Gram-negative and the spectrum on those bacteria [
8,
9,
10]. In most cases the antimicrobial effect of plant extracts on Gram-positive bacteria are attributed to compounds such as polyphenols, flavonoids and terpenes that easily cross the plasmatic membrane of Gram-positive bacteria whose lack an outer membrane and the lipopolysaccharide. However, the HS fraction of the hydroalcoholic extract of
T. corymbosus described here is rich in lipidic compounds such as acyl-glycerols, acyl-phosphoglycerol, acylphosphocholine and acylamides. In addition, porphyrinic compound derived from chlorophyll and diethyl phthalate were found.
Lysophosphatidylcholine (LPC) which is abundant in mammalian cells, serves as a mediator of inflammation and trigger of apoptosis has also been described as a cell signal in plants. The related lysophosphatidylcholine 17:1 was found in Leaf Surface of Wild Potato Solanum bulbocastanum and as confirmed by in vitro assays would be responsible for Inhibiting the fungi Phytophthora infestans [
11]. The antimicrobial effects of lysophosphatidylcholine are widely described against bacteria including direct effects against methicillin resistant
S. aureus or as a coadjutant increasing efficacy of colistin in Gram-negatives [
12,
13,
14]. Erucamide has been described by its properties reducing growth but also virulence of the plant pathogen
Ralstonia pseudosolanacearum [
15]. In a different study, erucamide was present in extracts of
Bacillus megaterium with antibacterial effects against plant pathogens
Agrobacterium tumefaciens,
Erwinia carotovora, and
Ralstonia solanacearum [
16]. While fatty acids and monoglycerides has been study for their potential inhibit viral and bacterial infections [
17,
18,
19,
20,
21,
22,
23]; studies in PG (diacylphosphogicerides), PI (phosphatidylinositol), PA (diacyl phosphatidic acids) scarce and refers to some effects in vivo and in vitro inhibiting infection of some viruses [
24,
25,
26].
The predominant presence of lipidic compounds in the HSF leads to hypothesizing that the antimicrobial effects may be due to disruption of membrane integrity or at least changes in permeability, as depicted in
Figure 8. Therefore, studies to determine permeability, because of membrane damage, were performed and confirmed the hypothesis in
S. aureus which resulted very sensitive in the antimicrobial assays (
Figure 7). This is a strong observation, because HSF presented significant antimicrobial effects not only on a standard strain, but also in clinical multi-resistant isolates of
S. aureus (
Figure 4 and
Table 4).
The described HSF was rich in lipidic and porphyrinic compounds. However, the whole original extract was rich in flavonoids, anthraquinones, tannins, and phenolic compounds between other species. Therefore, results from a previous study are consistent with this composition [
7]. The precipitation induced by adding methanol allowed purifying a fraction rich in lipidic compounds with surfactant activity, since the precipitate is hydro soluble. Such features are consistent with the composition of polar lipidic species, as evidenced by mass spectroscopy studies, Table and
Figure 5.
The antimicrobial profile observed for the hydrosoluble fraction (HSF) of
T. corymbosus may reflect a synergistic contribution among the lipidic and minor phenolic constituents identified by LC-MS. It is plausible that the amphiphilic molecules such as phosphatidylinositol (PI), phosphatidylglycerol (PG), and lysophosphatidylcholine (LPC) act not only through direct membrane perturbation but also by modulating bacterial stress responses and permeability, facilitating the entry of other bioactive metabolites. Similar synergistic effects between lipidic surfactant-like compounds and polyphenols have been reported in other plant-derived extracts, enhancing bactericidal activity particularly against Gram-positive pathogens [
8,
27] Furthermore, the moderate effects against selected Gram-negative strains such as
S. Typhi and
P. aeruginosa suggest that lipid-based molecules could partially overcome the outer membrane barrier, possibly by increasing lipopolysaccharide fluidity or interacting with membrane proteins involved in antibiotic resistance [
12,
14].
The ability of the HSF to inhibit multi-resistant
S. aureus isolates is especially relevant in the current context of antibiotic resistance. Plant-derived lipidic molecules, including lysophospholipids and long-chain amides like erucamide, have shown capacity to reduce bacterial virulence and biofilm formation, and to sensitize resistant strains to conventional antibiotics [
15,
16]. Therefore, the lipid-rich composition of T. corymbosus extract could provide a dual mechanism of action: direct membrane disruption and adjuvant effects that enhance antibiotic susceptibility. These findings open the possibility of developing combinatorial approaches using
T. corymbosus fractions as natural adjuvants to restore antibiotic efficacy, an area that warrants further pharmacodynamic and mechanistic exploration.
The antimicrobial effects might explain in part some of the uses, however we need to consider first the diversity of
T. corymbosus regarding their host and the subtractions of metabolites
T. corymbosus make as it fuses its vascular system to the vascular system of the host. Such differences have been addressed to establish differences between
T. corymbosus hosted by
Aristotelia chilensis and poplar [
1]. In addition,
T. corymbosus is one of at least three species commonly known under the name of quitral and possible all may have been used in traditional medicine.
4. Materials and Methods
4.1. Plant Material
Leaves and small branches of T. corymbosus were collected in El Paico, El Monte, RM, Chile (33°42′30.85″ S 71°02′11.92″ W). T. corymbosus was hosted in a S. babilonica. The collected material was validated by the specialist Scarlett Norambuena and deposited at the Herbarium of Facultad de Ciencias Químicas y Farmacéuticas, Universidad de Chile, under code number SQF#22.906. The leaves, flowers, fruits and small branches of T. corymbosus were dried for 15 days at 21 °C and crushed down in a porcelain mortar.
4.2. Plant Material
The extracts were prepared by a discontinuous method using 70% ethanol as dissolvent as previously described [
28]. In brief, 100 g of dry plant powder (flowers, fruits or leaves and small branches together) was macerated with 1 L of ethanol (70% in water) for 3 days at 60 rpm and 25 °C for 72 h. Following, the extract was filtered and rotovaped from 60-70 °C. When the extract was reduced to around 100 mL in mostly remaining water, 300 mL of methanol was added to keep extracting remaining water. Addition of methanol produced a muddy precipitate. The precipitate was vacuum filtered, while a tar-like insoluble fraction remained at the bottom of the original flask. The flowthrough fraction (in methanol and water) was rotovaped to dry. Finaly the three fractions were resuspended in 70% Ethanol for further characterization. Schematic representation of steps followed from extraction to antimicrobial activity essays and identification of molecules is shown in
Figure 2.
4.3. Phytochemical Characterization
To qualitatively pinpoint the main families of phytochemicals in the hydroalcoholic extract of
T. corymbosus obtained from leaves, flowers, and fruits, standard phytochemical tests were performed [
29,
30]. The tests performed include aluminum chloride for flavonoids, Keller–Killiani for cardiac glycosides, foam formation for saponins, Bornträger for anthraquinones, fluorescence for coumarins, Liebermann–Burchard for steroids and terpenes, and Dragendorff for alkaloids, flavonoids, and phenolic substances [
27]. Detailed explanations on performing these phytochemical tests have been outlined in the literature and are summarized in the supplementary materials included [
31,
32,
33,
34].
Employing the Folin–Ciocalteu method, as noted in previous studies, total polyphenols were quantified through a calibration curve of gallic acid (GAE) in distilled water at concentrations of 50, 100, 250, 350, and 500 μg/mL. Absorbance was measured at 765 nm [
35,
36]. Total flavonoids were measured three times.
4.4. Antimicrobial Activity Assays by an Agar Diffusion Test
Mueller–Hinton agar was prepared by pouring 20 mL of hot medium into 90 mm disposable Petri dishes. After solidification and drying in a culture cabinet, the agar surface was inoculated with a microorganism suspension (McFarland 0.5 in 0.9% NaCl) using a cotton swab and a rotaplate to obtain a uniform lawn. Wells (6 mm) were then punched and filled with 35 μL of either the extract or the vehicle, as required by each assay. Inhibition zone diameters were measured in three directions after 16 h incubation. Description of the method was previously published [
28]. All experiments were performed independently at least three times.
4.5. Minimum Inhibitory Concentration (MIC)
Base-two serial dilutions were prepared in either Potato-Dextrose broth (for yeasts) or LB-Luria (for bacteria). A flat-bottom 96-well plate was loaded in its first row with 200 μL of culture media containing 15 mg/mL of HSF in LB medium containing bacteria or yeast (from an overnight inoculum adding same volume to reach MacFarlan 0.5 in saline buffer), therefore, each column contained a different microorganism. The rest of the wells were filled with 100 µL of diluted bacteria or yeast, with the microorganism corresponding to each column, before carrying out the base-two dilutions. Following 16 hours of incubation at 30 °C, cultures’ turbidity was assessed by visual observation, the lower concentration capable of inhibiting growth was reported as the MIC [
37]. The procedure was repeated at least three times without variations.
4.6. LC-MS Analysis
4.6.1. Sample Preparation and LC-MS Analysis
The lyophilized HSF extract was resuspended and analyzed using an LC-MS system consisting of an Elute UHPLC chromatograph (Bruker Daltonik GmbH, Germany) coupled to a Compact ESI-TOF mass spectrometer (Bruker Daltonik GmbH, Germany) equipped with an electrospray ionization (ESI) source. Instrument control and data acquisition were performed using HyStar 4.0 software (Bruker Daltonik GmbH, Germany). Chromatographic separation was carried out on a Kinetex C18 column (100 × 2.1 mm; Phenomenex Inc., CA, USA). A 3 μL aliquot of each resuspended extract was injected using the following gradient program: 0.0–0.5 min, 12.0% B; 0.5–11.0 min, 12.0–99.0% B; 11.0–14.0 min, 99.0% B; 14.0–14.2 min, 99.0–12.0% B; and 14.2–18.0 min, 12.0% B. Mobile phase A consisted of 0.1% formic acid (v/v) in water, and mobile phase B consisted of 0.1% formic acid (v/v) in acetonitrile. The flow rate was set to 0.4 mL/min and the column temperature was maintained at 40 °C. Ionization was performed via electrospray at 4500 V, using nitrogen as nebulizing gas at 2.0 bar and 8 L/min, and as drying gas at 250 °C. Mass spectra were acquired in both positive and negative ion modes.
4.6.2. Data Processing and Compound Identification
Chromatographic and spectral data were visualized and processed using DataAnalysis 4.4 (Bruker Daltonik GmbH, Germany). Prior to downstream analyses, the spectral data were calibrated using the calibration peak at tR 0.1 min within the m/z range 50–1300, corresponding to sodium/formate ion clusters. Calibrated mass spectral data were exported in mzXML format as centroid spectra for further analyses. Compound identification was performed using the Global Natural Products Social Molecular Networking (GNPS) platform (
https://gnps.ucsd.edu) [
38]. The mzXML files were submitted to the Library Search workflow using all available spectral libraries. The search parameters were a precursor ion mass tolerance of ±0.025 Da and a fragment ion mass tolerance of ±0.02 Da; default settings were used for all other parameters. Tentative identifications were accepted when the difference between the experimental m/z (m/z-exp) and the theoretical library m/z (m/z-theo) was ≤ 10 ppm and when the modified cosine (MQ) score supported an acceptable spectral match [
38].
4.8. Analysis of Membrane Damage Using LIVE/DEAD BacLight Assay
Due to the abundance of lipidic molecules in the extract, with potential detergent activity, damage at the membrane level was evaluated using the LIVE/DEAD BacLight Bacterial Viability Kit which combines two dyes that stain nucleic acids. SYTO 9 dye penetrates all cells, staining those with intact membranes predominantly green. Propidium iodide only penetrates bacteria with damaged membranes, displacing SYTO 9 and resulting in red fluorescence. Therefore, intact cells remain predominantly green, while membrane-damaged cells turn red. The green/red fluorescence ratio serves as a quantitative measure of bacterial membrane integrity and viability [
39]. To quantify the damaged and intact bacterial cells, a culture of bacteria was exposed to 7.5 mg/L of the extract at 37 °C for 24 h. Fluorescence was measured using the Tube luminometer GloMax
® Multi JR detection system (Promega, Madison, WI, USA) using excitation wavelength at 480 and 490 nm and emission detected at 500 and 635nm (green and red filters E6073 and E6074 respectively). Ratio of green/red fluorescence was used to interpolate the fraction of viable and damaged cells from a G/R versus percentage of viable cells produced by using killing bacteria with 70% isopropanol and then mixed with intact bacteria to produce a calibration curve with well-known proportions of killed/alive cells. Visualization of the assay was performed using a Nikon Eclipse E400 fluorescence microscope using excitation wavelengths 488. Visualizations were at 500 and 635 wavelengths.
5. Conclusions
The traditional use of
Tristerix corymbosus (known locally as quitral, quintral, cutral, or ñipe) by the Mapuche people highlights its long-standing role in indigenous medicine for treating a variety of ailments. Ethnobotanical records describe the use of infusions and decoctions of its leaves and flowers for managing gastrointestinal ulcers, internal hemorrhages, sore throat, kidney pain, and hypercholesterolemia, as well as for their diuretic and astringent effects. These traditional applications are consistent with the pharmacological findings that support the antioxidant, anti-inflammatory, and wound-healing potential of this parasitic plant [
7,
29,
40].
Recent phytochemical investigations have identified high levels of polyphenols and flavonoids in
T. corymbosus, particularly in flower extracts, which contribute to its strong antioxidant and antibacterial activities [
1,
29,
40]. These findings suggest that the bioactive secondary metabolites responsible for their antioxidant properties may also underlie its antimicrobial effects. This correlation between traditional Mapuche use and experimental evidence reinforces the ethnopharmacological relevance of
T. corymbosus and supports its potential as a source of natural antimicrobial agents.
Author Contributions
Conceptualization, A.H., N.V. and M.R-D.; methodology, A.H., S.B., A.B., S.C.; software, A.B., A.H., S.B.; validation, S.C., A. C., C. M., B.S.; formal analysis, A.H. A.B., S.B., S.C., A.C., C. M., N.V.; investigation, A.H, N.V., M.R.; resources, AH., MR., B.S., S.B., N.V.; data curation, C.M., A.H, A.B., S.B, S.C., A.C.; writing—original draft preparation, A.H., M.R; writing—review and editing, A.H.; M.R.; J.E.; J.M.; visualization, A.H., A.B. C.M., A.C.; supervision, M.R., J.E., J.M; project administration, M.R., J. E., J. M.; funding acquisition, M.R.; B.S.; J.E.; J.M. All authors have read and agreed to the published version of the manuscript.”
Funding
This research was funded by Agencia Nacional de Investigación y Desarrollo, ANID Regular grant 1231676” and “The APC was funded by Programa de Apoyo e Incentivo a las publicaciones at PUCV”.
Acknowledgments
We thank Victor Ahumada for technical support in the initial part of this project. Parts of this work have been presented as the undergraduate dissertation of Consuelo Martinez-Contreras as part of the requirements to obtain the degree in Pharmacy at Universidad Andres Bello, Santiago, Chile. The authors have reviewed and edited the output and take full responsibility for the content of this publication.
Conflicts of Interest
The authors declare no conflicts of interest
Abbreviations
The following abbreviations are used in this manuscript:
| HSF |
Hydrosoluble fraction |
| LB |
Lysogeny broth |
| LD |
Linear dichroism |
| PG |
diacylphosphogicerides |
| PI |
phosphatidylinositol |
| PA |
diacyl phosphatidic acids |
References
- Torres, P.; Saldaña, C.; Ortega, R.; González, C. DETERMINATION OF REDUCING POWER AND PHYTOCHEMICAL PROFILE OF THE CHILEAN MISTLETOE “QUINTRAL” (Tristerix Corymbosus (L) Kuijt) HOSTED IN “MAQUI” (Aristotelia Chilensis), “HUAYÚN” (Rhaphitamnus Spinosus) AND “POPLAR” (Populus Nigra). Journal of the Chilean Chemical Society 2019, 64, 4645–4650. [Google Scholar] [CrossRef]
- Houghton, P.J.; Manby, J. Medicinal Plants of the Mapuche. Journal of Ethnopharmacology 1985, 13, 89–103. [Google Scholar] [CrossRef]
- Imbimbo, P.; Fontanarosa, C.; Amoresano, A.; Monti, D.M.; Battaglia, G.; Nicoletti, M.; Spinelli, M.; Schaller, G.; Rocco, V. Phytochemical Composition and Antioxidant Activity of a Viscum Album Mother Tincture. Plants 2025, 14, 2762. [Google Scholar] [CrossRef]
- Mapfumari, S.; Nogbou, N.-D.; Musyoki, A.; Gololo, S.; Mothibe, M.; Bassey, K. Phytochemical Screening, Antioxidant and Antibacterial Properties of Extracts of Viscum Continuum E. Mey. Ex Sprague, a South African Mistletoe. Plants (Basel) 2022, 11, 2094. [Google Scholar] [CrossRef]
- Mushtaq, W.; Ishtiaq, M.; Maqbool, M.; Mazhar, M.W.; Casini, R.; Abd-ElGawad, A.M.; Elansary, H.O. Green Synthesis of Zinc Oxide Nanoparticles Using Viscum Album Extracts: Unveiling Bioactive Compounds, Antibacterial Potential, and Antioxidant Activities. Plants (Basel) 2023, 12, 2130. [Google Scholar] [CrossRef]
- Phytochemical Screening and Antimicrobial Activities of Stem, Leaves and Fruit Extracts of Viscum Album L. Journal of Pure and Applied Microbiology 2018.
- Simirgiotis, M.J.; Quispe, C.; Areche, C.; Sepúlveda, B. Phenolic Compounds in Chilean Mistletoe (Quintral, Tristerix Tetrandus) Analyzed by UHPLC–Q/Orbitrap/MS/MS and Its Antioxidant Properties. Molecules 2016, 21, 245. [Google Scholar] [CrossRef] [PubMed]
- Álvarez-Martínez, F.J.; Barrajón-Catalán, E.; Herranz-López, M.; Micol, V. Antibacterial Plant Compounds, Extracts and Essential Oils: An Updated Review on Their Effects and Putative Mechanisms of Action. Phytomedicine 2021, 90, 153626. [Google Scholar] [CrossRef]
- Niño, J.; Mosquera, O.M.; Correa, Y.M. Antibacterial and Antifungal Activities of Crude Plant Extracts from Colombian Biodiversity. Revista de Biología Tropical 2012, 60, 1535–1542. [Google Scholar] [CrossRef]
- Akin, M.; Saki, N. Antimicrobial, DPPH Scavenging and Tyrosinase Inhibitory Activities of Thymus Vulgaris, Helichrysum Arenarium and Rosa Damascena Mill. Ethanol Extracts by Using TLC Bioautography and Chemical Screening Methods. Journal of Liquid Chromatography & Related Technologies 2019, 42, 204–216. [Google Scholar] [CrossRef]
- Gorzolka, K.; Perino, E.H.B.; Lederer, S.; Smolka, U.; Rosahl, S. Lysophosphatidylcholine 17:1 from the Leaf Surface of the Wild Potato Species Solanum Bulbocastanum Inhibits Phytophthora Infestans. J. Agric. Food Chem. 2021, 69, 5607–5617. [Google Scholar] [CrossRef]
- Miró-Canturri, A.; Ayerbe-Algaba, R.; Jiménez-Mejías, M.E.; Pachón, J.; Smani, Y. Efficacy of Lysophosphatidylcholine as Direct Treatment in Combination with Colistin against Acinetobacter Baumannii in Murine Severe Infections Models. Antibiotics 2021, 10, 194. [Google Scholar] [CrossRef]
- Miyazaki, H.; Midorikawa, N.; Fujimoto, S.; Miyoshi, N.; Yoshida, H.; Matsumoto, T. Antimicrobial Effects of Lysophosphatidylcholine on Methicillin-Resistant Staphylococcus Aureus. Therapeutic Advances in Infectious Disease 2017, 4, 89–94. [Google Scholar] [CrossRef]
- Yadav, J.; Ismaeel, S.; Qadri, A. Lysophosphatidylcholine Potentiates Antibacterial Activity of Polymyxin B. Antimicrobial Agents and Chemotherapy 2020, 64. [Google Scholar] [CrossRef]
- Li, P.; Wang, S.; Liu, M.; Dai, X.; Shi, H.; Zhou, W.; Sheng, S.; Wu, F. Antibacterial Activity and Mechanism of Three Root Exudates from Mulberry Seedlings against Ralstonia Pseudosolanacearum. Plants 2024, 13, 482. [Google Scholar] [CrossRef]
- Xie, Y.; Peng, Q.; Ji, Y.; Xie, A.; Yang, L.; Mu, S.; Li, Z.; He, T.; Xiao, Y.; Zhao, J.; et al. Isolation and Identification of Antibacterial Bioactive Compounds From Bacillus Megaterium L2. Front. Microbiol. 2021, 12. [Google Scholar] [CrossRef] [PubMed]
- Agassandian, M.; Mallampalli, R.K. Surfactant Phospholipid Metabolism. Biochimica et Biophysica Acta (BBA) - Molecular and Cell Biology of Lipids 2013, 1831, 612–625. [Google Scholar] [CrossRef]
- Field, C.J. The Immunological Components of Human Milk and Their Effect on Immune Development in Infants1,2. The Journal of Nutrition 2005, 135, 1–4. [Google Scholar] [CrossRef] [PubMed]
- Isaacs, C.E.; Thormar, H. The Role of Milk-Derived Antimicrobial Lipids as Antiviral and Antibacterial Agents. Adv Exp Med Biol 1991, 310, 159–165. [Google Scholar] [CrossRef]
- Isaacs, C.E.; Litov, R.E.; Thormar, H. Antimicrobial Activity of Lipids Added to Human Milk, Infant Formula, and Bovine Milk. J Nutr Biochem 1995, 6, 362–366. [Google Scholar] [CrossRef] [PubMed]
- Isaacs, C.E.; Kashyap, S.; Heird, W.C.; Thormar, H. Antiviral and Antibacterial Lipids in Human Milk and Infant Formula Feeds. Arch Dis Child 1990, 65, 861–864. [Google Scholar] [CrossRef]
- Sprong, R.C.; Hulstein, M.F.; Van der Meer, R. Bactericidal Activities of Milk Lipids. Antimicrob Agents Chemother 2001, 45, 1298–1301. [Google Scholar] [CrossRef] [PubMed]
- Sun, C.Q.; O’Connor, C.J.; Roberton, A.M. The Antimicrobial Properties of Milkfat after Partial Hydrolysis by Calf Pregastric Lipase. Chem Biol Interact 2002, 140, 185–198. [Google Scholar] [CrossRef]
- Hilmarsson, H.; Kristmundsdóttir, T.; Thormar, H. Virucidal Activities of Medium- and Long-Chain Fatty Alcohols, Fatty Acids and Monoglycerides against Herpes Simplex Virus Types 1 and 2: Comparison at Different pH Levels. APMIS 2005, 113, 58–65. [Google Scholar] [CrossRef] [PubMed]
- Numata, M.; Kandasamy, P.; Nagashima, Y.; Posey, J.; Hartshorn, K.; Woodland, D.; Voelker, D.R. Phosphatidylglycerol Suppresses Influenza A Virus Infection. Am J Respir Cell Mol Biol 2012, 46, 479–487. [Google Scholar] [CrossRef]
- Numata, M.; Kandasamy, P.; Nagashima, Y.; Fickes, R.; Murphy, R.C.; Voelker, D.R. Phosphatidylinositol Inhibits Respiratory Syncytial Virus Infection. J Lipid Res 2015, 56, 578–587. [Google Scholar] [CrossRef]
- Dubale, S.; Kebebe, D.; Zeynudin, A.; Abdissa, N.; Suleman, S. Phytochemical Screening and Antimicrobial Activity Evaluation of Selected Medicinal Plants in Ethiopia. J Exp Pharmacol 2023, 15, 51–62. [Google Scholar] [CrossRef] [PubMed]
- Rodríguez-Díaz, M.; Pérez, F.E.; Manosalva, P.M.; Cerda, J.I.; Martínez-Contreras, C.F.; Mora, A.Y.; Villagra, N.A.; Bucarey, S.A.; Barriga, A.; Escobar, J.; et al. Antimicrobial Activity and Phytochemical Characterization of Baccharis Concava Pers., a Native Plant of the Central Chilean Coast. Molecules 2024, 29, 1654. [Google Scholar] [CrossRef]
- Rebolledo, V.; Otero, M.C.; Delgado, J.M.; Torres, F.; Herrera, M.; Ríos, M.; Cabañas, M.; Martinez, J.L.; Rodríguez-Díaz, M. Phytochemical Profile and Antioxidant Activity of Extracts of the Peruvian Peppertree Schinus Areira L. from Chile. Saudi Journal of Biological Sciences 2021, 28, 1052–1062. [Google Scholar] [CrossRef]
- Ndezo Bisso, B.; Njikang Epie Nkwelle, R.; Tchuenguem Tchuenteu, R.; Dzoyem, J.P. Phytochemical Screening, Antioxidant, and Antimicrobial Activities of Seven Underinvestigated Medicinal Plants against Microbial Pathogens. Adv Pharmacol Pharm Sci 2022, 2022, 1998808. [Google Scholar] [CrossRef]
- María, R.; Shirley, M.; Xavier, C.; Jaime, S.; David, V.; Rosa, S.; Jodie, D. Preliminary Phytochemical Screening, Total Phenolic Content and Antibacterial Activity of Thirteen Native Species from Guayas Province Ecuador. Journal of King Saud University - Science 2018, 30, 500–505. [Google Scholar] [CrossRef]
- Pandey, A.; Tripathi, S. Concept of Standardization, Extraction and Pre Phytochemical Screening Strategies for Herbal Drug. J Pharmacogn Phytochem 2014, 2, 115–119. [Google Scholar]
- Morsy, N. Phytochemical Analysis of Biologically Active Constituents of Medicinal Plants. Main Group Chemistry 2014, 13, 7–21. [Google Scholar] [CrossRef]
- Shaikh, J.R.; Patil, M.K. Qualitative Tests for Preliminary Phytochemical Screening: An Overview. Int. J. Chem. Stud. 2020, 8, 603–608. [Google Scholar] [CrossRef]
- Singleton, V.L.; Rossi, J.A. Colorimetry of Total Phenolics with Phosphomolybdic-Phosphotungstic Acid Reagents. Am J Enol Vitic. 1965, 16, 144–158. [Google Scholar] [CrossRef]
- Determination of Total Phenolics - Waterhouse - 2002 - Current Protocols in Food Analytical Chemistry - Wiley Online Library. Available online: https://currentprotocols.onlinelibrary.wiley.com/doi/abs/10.1002/0471142913.fai0101s06 (accessed on 21 October 2025).
- Villagra, N.A.; Hidalgo, A.A.; Santiviago, C.A.; Saavedra, C.P.; Mora, G.C. SmvA, and Not AcrB, Is the Major Efflux Pump for Acriflavine and Related Compounds in Salmonella Enterica Serovar Typhimurium. Journal of Antimicrobial Chemotherapy 2008, 62, 1273–1276. [Google Scholar] [CrossRef]
- Wang, M.; Carver, J.J.; Phelan, V.V.; Sanchez, L.M.; Garg, N.; Peng, Y.; Nguyen, D.D.; Watrous, J.; Kapono, C.A.; Luzzatto-Knaan, T.; et al. Sharing and Community Curation of Mass Spectrometry Data with GNPS. Nat Biotechnol 2016, 34, 828–837. [Google Scholar] [CrossRef]
- Stiefel, P.; Schmidt-Emrich, S.; Maniura-Weber, K.; Ren, Q. Critical Aspects of Using Bacterial Cell Viability Assays with the Fluorophores SYTO9 and Propidium Iodide. BMC Microbiology 2015, 15, 36. [Google Scholar] [CrossRef] [PubMed]
- Velásquez, P.; Muñoz-Carvajal, E.; Luengo, M.; Bustos, D.; Galdames, F.; Gómez, M.; Montenegro, G.; Giordano, A. Phytochemical Screening and Biological Properties of Quintral Flower Polyphenolic Fractions. Nat Prod Res 2024, 1–5. [Google Scholar] [CrossRef] [PubMed]
Figure 2.
Workflow leading to evaluation of antimicrobial activity and phytochemical characterization of hydroalcoholic extract of T. corymbosus. Extracts were prepared in 70% ethanol and rotovaped at 60-70 °C. To keep drying the extract, methanol was added, producing separation of the extract in a soluble fraction, a brown powder and a tar-like residue. The brown powder turned out to be more active and was further characterized by its antimicrobial activity and phytochemically using HPLC-MS.
Figure 2.
Workflow leading to evaluation of antimicrobial activity and phytochemical characterization of hydroalcoholic extract of T. corymbosus. Extracts were prepared in 70% ethanol and rotovaped at 60-70 °C. To keep drying the extract, methanol was added, producing separation of the extract in a soluble fraction, a brown powder and a tar-like residue. The brown powder turned out to be more active and was further characterized by its antimicrobial activity and phytochemically using HPLC-MS.
Figure 3.
inhibition haloes produced by the HSF of T. corymbosus. A well diffusion assay was used to evaluate antimicrobial effects of the HSF of T. corymbosus on Gram-positives, Gram-negatives and Candida albicans, a yeast. The figure shows some of the tested bacteria in technical triplicates and the vehicle in the central well.
Figure 3.
inhibition haloes produced by the HSF of T. corymbosus. A well diffusion assay was used to evaluate antimicrobial effects of the HSF of T. corymbosus on Gram-positives, Gram-negatives and Candida albicans, a yeast. The figure shows some of the tested bacteria in technical triplicates and the vehicle in the central well.
Figure 4.
Haloes of inhibition produced by the HSF of
T. corymbosus in clinical isolated bacteria. A well diffusion assay was used to evaluate antimicrobial effects of the hydro-soluble extract of
T. corymbosus on clinical isolated
S. aureus and clinical isolated Gram-negatives such as
K. pneumoniae,
M. morganii,
E. coli,
E. cloacae and
E. aerogenes. The antibiogram for all clinical isolated tested and their antibiotics resistant profile is provided in
Table 4. The experiments were performed at least three times.
Figure 4.
Haloes of inhibition produced by the HSF of
T. corymbosus in clinical isolated bacteria. A well diffusion assay was used to evaluate antimicrobial effects of the hydro-soluble extract of
T. corymbosus on clinical isolated
S. aureus and clinical isolated Gram-negatives such as
K. pneumoniae,
M. morganii,
E. coli,
E. cloacae and
E. aerogenes. The antibiogram for all clinical isolated tested and their antibiotics resistant profile is provided in
Table 4. The experiments were performed at least three times.
Figure 5.
Molecular profile of the HSF obtained from the ethanolic extract of T. corymbosus. Chromatogram obtained from the negative polarity detection mode (a) and Chromatogram obtained for positive polarity detection mode (b) of the HSF from T. corymbosus. The numbered peaks were tentatively identified using a spectrometric database.
Figure 5.
Molecular profile of the HSF obtained from the ethanolic extract of T. corymbosus. Chromatogram obtained from the negative polarity detection mode (a) and Chromatogram obtained for positive polarity detection mode (b) of the HSF from T. corymbosus. The numbered peaks were tentatively identified using a spectrometric database.
Figure 6.
HSF obtained from T. corymbosus is rich in lipidic compounds. Identified molecules of positive and negative ion modes include (a) diethyl phthalate a compound regarded as both synthetic and naturally occurring. (b) Lysophosphatidylcholine (LPC) is a acylphosphocholine. (c) Is a porphyrinic compound representative of several related molecules detected in the extract. (d) shows the most representative diacylglycerol molecule corresponding to DAG (16:0/18:4) formula. (e) (Z)-13-docosenamide known as erucamide, a natural molecule derived from erucic acid found in plants. For (d), (f), (g) and (h), the formulae with the most representative insaturations are shown, albeit we cannot specify the precise position of the double bonds in the acyl-moiety of each chemical species.
Figure 6.
HSF obtained from T. corymbosus is rich in lipidic compounds. Identified molecules of positive and negative ion modes include (a) diethyl phthalate a compound regarded as both synthetic and naturally occurring. (b) Lysophosphatidylcholine (LPC) is a acylphosphocholine. (c) Is a porphyrinic compound representative of several related molecules detected in the extract. (d) shows the most representative diacylglycerol molecule corresponding to DAG (16:0/18:4) formula. (e) (Z)-13-docosenamide known as erucamide, a natural molecule derived from erucic acid found in plants. For (d), (f), (g) and (h), the formulae with the most representative insaturations are shown, albeit we cannot specify the precise position of the double bonds in the acyl-moiety of each chemical species.
Figure 7.
HSF obtained from T. corymbosus induces bacterial death by affecting membrane stability. Incubation with 7.5 mg/mL of HSF was sufficient to inhibit growth of S. aureus by affecting membrane integrity. Treatment with HSF promotes permeability and kills cells facilitating entry of propidium iodine (PI) resulting in increased red fluorescence (a). As PI enters the bacterial cell, it displaces SYTO 9, decreasing green fluorescence (b). The capabilities of PI and SYTO 9 of permeating dying and intact cells allows calibrating the ratio of green/red fluorescence versus percentage of live cells, to finally estimate viable cells in around 11.9% and the remaining 88.1% with membrane damage (c-d).
Figure 7.
HSF obtained from T. corymbosus induces bacterial death by affecting membrane stability. Incubation with 7.5 mg/mL of HSF was sufficient to inhibit growth of S. aureus by affecting membrane integrity. Treatment with HSF promotes permeability and kills cells facilitating entry of propidium iodine (PI) resulting in increased red fluorescence (a). As PI enters the bacterial cell, it displaces SYTO 9, decreasing green fluorescence (b). The capabilities of PI and SYTO 9 of permeating dying and intact cells allows calibrating the ratio of green/red fluorescence versus percentage of live cells, to finally estimate viable cells in around 11.9% and the remaining 88.1% with membrane damage (c-d).
Figure 8.
Lipidic compounds found in HSF obtained from T. corymbosus affect membrane permeability. According to results and literature, lipidic compounds found in plant extracts exert antimicrobial effects by increasing permeability.
Figure 8.
Lipidic compounds found in HSF obtained from T. corymbosus affect membrane permeability. According to results and literature, lipidic compounds found in plant extracts exert antimicrobial effects by increasing permeability.
Table 1.
Qualitative determination of secondary metabolites in ethanolic extracts of T. corymbosus.
Table 1.
Qualitative determination of secondary metabolites in ethanolic extracts of T. corymbosus.
| compounds tested |
Assay |
leaves |
flowers |
fruits |
| alkaloids |
Dragendorff |
- |
+ |
- |
| Mayer |
- |
- |
- |
| Wagner |
- |
- |
- |
| anthraquinones |
Bornträger |
+ |
- |
+ |
| Saponins |
Foam formation |
+ |
- |
+ |
| cardiac glycosides |
Keller-Killiani |
+ |
- |
+ |
| flavonoids |
Shinoda |
+ |
- |
- |
| Aluminum chloride |
- |
- |
- |
| Alkaline reagent test |
+ |
- |
+ |
| reducing sugars |
Fehling |
- |
+ |
+ |
| steroids and terpenes |
Liebermann-Burchard |
+ |
+ |
+ |
| Salkowski |
- |
+ |
- |
| amino acids & proteins |
Ninhydrin |
- |
- |
- |
| Tannins and phenolic |
Ferric chloride |
+ |
+ |
+ |
| Carbohydrates |
Molish |
- |
- |
+ |
| coumarins |
Fluorescence under UV |
- |
- |
- |
Table 4.
Aimicrobial activity of the hydroalcoholic extract of T. corymbosus against a panel of clinical bacterial strains.
Table 4.
Aimicrobial activity of the hydroalcoholic extract of T. corymbosus against a panel of clinical bacterial strains.
| Microorganism |
Inhibition haloes (mm) |
MIC (mg/L) |
Resistance found |
|
Staphylococcus. aureus H1 |
29.33 ± 0.67 |
7.50 mg/L |
AmpR
|
|
Staphylococcus aureus H2 |
35.67 ± 0.58 |
7.50 mg/L |
AmpR, CipR, ImiR
|
|
Staphylococcus. aureus H4 |
32.33 ± 0.58 |
7.50 mg/L |
AmpR, CipR, ImiR
|
|
Staphylococcus. aureus H5 |
31.33 ± 0.58 |
7.50 mg/L |
AmpR, CipR, ImiR
|
|
Klebsiella. pneumoniae H1 |
11.00 ± 0.00 |
15.00 mg/L |
AmpR
|
|
Morganella morganii H1 |
8.67 ± 0.88 |
15.00 mg/L |
AmpR
|
|
Escherichia coli H1 |
9.33 ± 0.58 |
15.00 mg/L |
AmpR, CipR, TetR
|
|
Enterobacter cloacae H1 |
26.67 ± 1.00 |
15.00 mg/L |
AmpR, CipR, TetR
|
|
Enterobacter aerogenes H6 |
6.00 ± 0.00 |
15.00 mg/L |
AmpR, CipR, ImiR
|
| The results are average of three independent experiments ± standard error. MIC, minimal inhibitory concentration. All strains correspond to clinical isolated bacteria maintained in the laboratory and collected by the Central Clinical Laboratory at Universidad the Chile during 2013-2016. AmpR, CipR, TetR and ImiR correspond to ampicillin, ciprofloxacin, tetracycline and Imipenem resistant phenotypes. |
Table 5.
HSF powder: identification of detected compounds.
Table 5.
HSF powder: identification of detected compounds.
| Positive polarity |
|---|
| Peak |
Rt (min) |
Putative identification |
Formula |
Ion |
m/z-theo |
m/z-exp |
error (ppm) |
MQ score |
Classification |
| 3 |
6.2 |
Diethyl phthalate |
C12H14O4 |
[M+H]+ |
223.0965 |
223.0959 |
2.6 |
0.966 |
- |
| 4 |
8.2 |
LPC(16:0) |
C24H50NO7P |
[M+H]+ |
496.3398 |
496.3432 |
-6.9 |
0.949 |
Glycerophospholipids |
| 8 |
10.6 |
3,10S-Hydroxypheophorbide A |
C35H36N4O6 |
[M+H]+ |
609.2708 |
609.2654 |
8.8 |
0.746 |
Tetrapyrroles |
| 10 |
10.9 |
3,10S-Hydroxypheophorbide A |
C35H36N4O6 |
[M+H]+ |
609.2708 |
609.2710 |
-0.4 |
0.746 |
Tetrapyrroles |
| 11 |
11.2 |
Pheophorbide A |
C35H36N4O5 |
[M+H]+ |
593.2758 |
593.2750 |
1.4 |
0.963 |
Tetrapyrroles |
| 12 |
11.4 |
DAG (16:0/18:4) |
C37H64O5 |
[M+H]+ |
589.4827 |
589.4799 |
4.7 |
0.712 |
Glycerolipids |
| |
11.4 |
Pheophorbide A |
C35H36N4O5 |
[M+H]+ |
593.2758 |
593.2764 |
-0.9 |
0.963 |
Tetrapyrroles |
| 14 |
11.5 |
Pyropheophorbide A |
C33H34N4O3 |
[M+H]+ |
535.2704 |
535.2704 |
-0.1 |
0.742 |
Tetrapyrroles |
| |
11.5 |
DAG (16:0/18:4) |
C37H64O5 |
[M+H]+ |
589.4827 |
589.4861 |
-5.8 |
0.756 |
Glycerolipids |
| 15 |
11.6 |
DAG (16:0/18:4) |
C37H64O5 |
[M+H]+ |
589.4827 |
589.4807 |
3.3 |
0.758 |
Glycerolipids |
| 16 |
11.7 |
DAG (16:0/18:4) |
C37H64O5 |
[M+H]+ |
589.4827 |
589.4812 |
2.5 |
0.748 |
Glycerolipids |
| 18 |
12.1 |
Pheophytin A |
C55H74N4O5 |
[M+H]+ |
871.5732 |
871.5714 |
2.1 |
0.827 |
Tetrapyrroles |
| 22 |
13.0 |
13-Docosenamide, (Z)- |
C22H43NO |
[M+H]+ |
338.3417 |
338.3413 |
1.3 |
0.830 |
Fatty acid amides |
| Negative polarity |
| Peak |
Rt (min) |
Putative identification |
Formula |
Ion |
m/z-theo |
m/z-exp |
error (ppm) |
MQ score |
Classification |
| 5 |
10.0 |
PG(16:1/18:3) |
C40H71O10P |
[M-H]- |
741.4712 |
741.4652 |
8.1 |
0.715 |
Glycerophospholipids |
| |
10.0 |
PI(16:0/18:2) |
C43H79O13P |
[M-H]- |
833.5186 |
833.5160 |
3.1 |
0.899 |
Fatty acids |
| 6 |
10.5 |
PG(16:1/18:3) |
C40H71O10P |
[M-H]- |
741.4712 |
741.4686 |
3.5 |
0.713 |
Glycerophospholipids |
| |
10.5 |
PI(16:0/18:2) |
C43H79O13P |
[M-H]- |
833.5186 |
833.5140 |
5.5 |
0.928 |
Fatty acids |
| 7 |
11.1 |
PI(16:0/18:2) |
C43H79O13P |
[M-H]- |
833.5186 |
833.5163 |
2.7 |
0.884 |
Fatty acids |
| 8 |
11.3 |
PI(16:0/18:2) |
C43H79O13P |
[M-H]- |
833.5186 |
833.5163 |
2.7 |
0.896 |
Fatty acids |
| 15 |
13.4 |
PA(18:2/18:2) |
C39H69O8P |
[M-H]- |
695.4657 |
695.4592 |
9.4 |
0.842 |
Glycerophospholipids |
| 16 |
13.6 |
PA(18:2/18:2) |
C39H69O8P |
[M-H]- |
695.4657 |
695.4643 |
2.1 |
0.798 |
Glycerophospholipids |
|
Disclaimer/Publisher’s Note: The statements, opinions and data contained in all publications are solely those of the individual author(s) and contributor(s) and not of MDPI and/or the editor(s). MDPI and/or the editor(s) disclaim responsibility for any injury to people or property resulting from any ideas, methods, instructions or products referred to in the content. |
© 2025 by the authors. Licensee MDPI, Basel, Switzerland. This article is an open access article distributed under the terms and conditions of the Creative Commons Attribution (CC BY) license (http://creativecommons.org/licenses/by/4.0/).